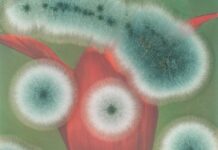
Ausstellung: TOUCH NATURE / Kulturforum New York

Advokaten 1938 / Kulturforum New York
7. März 2024
Am 7. März wird am Österreichischen Kulturforum New York die zweite Auflage des Buches Advokaten 1938: The fate of the lawyers and...
Touch Nature – Closing Panel: From Exhibit to Action / Kulturforum New York
Am 22. Februar wird am Österreichischen Kulturforum New York die Abschlussveranstaltung zur rezenten Ausstellung “Touch Nature“ stattfinden. Die in der Ausstellung präsentierten Kunstwerke untersuchen...
Musik aus Theresienstadt / Kulturforum New York
31. Januar 2024
Am 31. Januar wird im Österreichischen Kulturforum New York das Konzert Theresienstadt abgehalten.
Im gleichnamigen Nazi-Ghetto schufen Künstler:innen trotz Hunger, Seuchengefahr, inhumaner...
“Totem for Humanity – Tree of Life” (2023) / Kulturforum New York
18. November 2023 – 14. Jänner 2024
Zum ersten Mal präsentiert das Österreichische Kulturforum New York die ortsspezifische Installation "Totem for Humanity - Tree...
Präsentation der Originalgeige Wolfgang Amadeus Mozarts / Kulturforum New York
12. Dezember 2023
Das Österreichische Kulturforum New York freut sich, in Zusammenarbeit mit der Internationalen Stiftung Mozarteum die Originalgeige von Wolfgang Amadeus Mozart erstmals in...
“A Theater that Brings Joy Back to People”: 150 Years Max Reinhardt / Kulturforum...
29. November 2023
Anlässlich des 150. Geburtstages und des 80. Todestages des österreichischen Theater- und Filmregisseurs Max Reinhardt, organisiert das Österreichische Kulturforum New York eine...
Fairytales and Fantasies – An Enchanting Musical Journey / Kulturforum New York
14. und 15. November 2023
Am 15. November wird am Österreichischen Kulturforum New York ein Konzert unter dem Titel Fairytales and Fantasies - An Enchanting...
Atmospheres / Kulturforum New York
Ausstellungseröffnung: 13. November 2023Laufzeit der Ausstellung: 14. November 2023 – 13. Januar 2024
Am 13. November wird am Österreichischen Kulturforum New York die Ausstellung Atmospheres...
A(R)Talk 03 Margarete Schütte-Lihotzky. Architecture, Politics, Gender / Kulturforum New York
19. Oktober 2023
Im Rahmen der A(R)Talk-Serie des Österreichischen Kulturforums New York (ÖKF New York) werden sich am 26. Oktober am ÖKF New York die...
Ausstellung: TOUCH NATURE / Kulturforum New York
5. Oktober 2023 – 25. Februar 2024
TOUCH NATURE ist der Titel der neuen Ausstellung in der Galerie des Österreichischen Kulturforums in New York. Die...